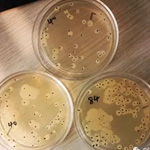

主要成分:高活性枯草芽孢杆菌及其代谢产物。
包装规格:25kg/袋。
产品规格:200× 108 CFU/g、1000× 108CFU/g、2000× 108 CFU/g。
保质期:18个月。
贮藏条件:通风、干燥、遮光、常温储存。

主要成分:高活性枯草芽孢杆菌及其代谢产物。
包装规格:25kg/袋。
产品规格:200× 108 CFU/g、1000× 108CFU/g、2000× 108 CFU/g。
保质期:18个月。
贮藏条件:通风、干燥、遮光、常温储存。
免责声明
本信息以及所有进一步的技术建议均是基于我方现有的知识和经验。但是,该等信息及技术建议并不意味着我方应承担任何债务或其他法律责任,包括有关现有带三方知识产权尤其是专利权方面的责任。特别是,我方无意作出或暗示的担保或保证。我方保留基于技术进步或进一步开发而作出任何变更的权利。客户仍有义务对所买产品进行仔细检验和测试。本说明所述的产品性能应当经测试确定,该等测试应仅由有资质的专家进行,并由客户独立负责。引用其他公司使用的商号并不表示推荐任何产品,亦不暗示不能使用类似产品。在任何情况下,山东天润和生物工程有限公司不承担读者基于对这些资料的信赖或使用而遭受的任何损害。读者应自行对资料的解释或使用而产生的后果承担责任。关于网站产品用户须知:网站所展示的所有产品内容仅代表公司对外展示的我公司产品广告宣传,如有任何疑问,请电话联系我们确认产品的参数、性能、使用环境等详细信息,所有访问本公司网页的人员均视为同意并接受本用户须知,谢谢!